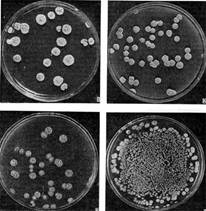

| Скачать .docx | Скачать .pdf |
Курсовая работа: Мікробний антогонізм як основа використання антибіотиків
Міністерство освіти і науки України
Чернігівський державний педагогічний університет імені Т.Г. Шевченка
Хіміко-біологічний факультет
Кафедра загальної біології
КУРСОВА РОБОТА
МІКРОБНИЙ АНТОГОНІЗМ ЯК ОСНОВА ВИКОРИСТАННЯ АНТИБІОТИКІВ
Виконала:
студент ІV курсу
Івченко І.М.
Науковий керівник:
к. б. н, доц. кафедри
загальної біології
Смикун Н.В.
Чернігів - 200 8
Зміст
Вступ
Розділ 1 Мікробний антогонізм: види та механізм дії
1.1 Поняття про мікробний антогонізм
1.2 Основні види антогонізму
1.3 Антагонізм у світі мікробів
1.4 Механізм мікробного антагонізму
Розділ 2 Антибіотики та їх використання
2.1 Роль антибіотиків у біоценозах
2.2 Поняття про антибіотики
2.3 Дія антибіотиків на мікроорганізми
2.4 Основні вимоги до антибіотиків
Висновки
Список використаних джерел
Вступ
Постійне удосконалення технологій і рецептур продуктів, що випускаються, привело до створення пробіотиків, що у сучасних умовах займають ведуче місце в профілактиці і комплексній терапії цілого ряду захворювань. Дії цих біологічних препаратів засновано на такому явищі як "мікробний антагонізм". Як нормальна флора вони інгибують ріст інших мікроорганізмів (патогенних і умовно-патогенних) у результаті конкуренції за джерело живлення, змінюють рН і вміст оксигену, тим самим знижуючи їхній рівень до стану, при якому патогенна флора гине.
Причини антагоністичної дії або самого механізму цього біологічного явища досить різноманітні. Ще Пастер стверджував, що припинення розмноження і загибель бактеріальних клітин у старих культурах, як і гноблення одного виду бактерій іншими в змішаних культурах або у тваринному організмі, обумовлюються виснаженням харчових властивостей середовища. Ця "теорія виснаження поживного" середовища - найбільш проста і сама рання зі спроб пояснення феномена антагонізму бактерій.
В даний час більшість дослідників пояснюють прояв антагоністичних впливів переважно особливими продуктами обміну, виділеними антагоністами.
Мета роботи полягає в тому, щоб охаратктеризувати мікробний антогонізм, йогов иди та застосування в антибіотикотерапії.
Основними завданнями роботи є:
1) дати характеристику мікробного антогонізму;
2) охарактеризувати основні види антогонізму та механізм дії;
3) розглянути застосування мікробного антогонізму при використанні антибіотиків.
Розділ 1 Мікробний антогонізм: види та механізм дії
1. 1 Поняття про мікробний антогонізм
Антагонізм мікробний - пригнічення життєдіяльності одного мікроба іншим. Одна з форм взаємин мікробів в асоціаціях. Антагонізм мікробний є принциповою основою одержання і застосування антибіотиків. Антагонізм мікробів широко використовується у ветеринарії для профілактики і лікування різних хвороб, головним чином шлунково-кишкових. Наприклад, багато штамів кишкової палички здатні привокувати розвиток і знищувати стрептококів, стафілококів, сибіреязвенних паличок, сальмонел, збудників злоякісного набряку туберкульозу.
У 1929 Олександр Флемінг, спостерігаючи антагонізм Penіcіllіum notatum і стафілокока в змішаній культурі, відкрив пеніцилін і припустив можливість його застосування в лікувальних цілях. Антагоністичні відносини між хвороботворними для рослин мікробами і непатогенними мікроорганізмами ґрунту, виявлені в змішаних культурах, зацікавили фітопатологів, і вони спробували використовувати цей феномен для боротьби з хворобами рослин. Було відомо, що в ґрунті присутній певний грибок, що зменшує відпрівання паростків; у 1936 з культури цього грибка був виділений антибіотик, що одержала назву гліотоксин. Це відкриття підтвердило значення антибіотиків як засобу профілактики захворювань.
Серед перших дослідників, що зайнялися цілеспрямованим пошуком антибіотиків, був Р.Дюбо. Проведені ним і його співробітниками експерименти привели до відкриття антибіотиків, вироблюваних деякими ґрунтовими бактеріями, їх виділенню в чистому вигляді і використанню в клінічній практиці. У 1939 Дюбо одержав тиротрицин - комплекс антибіотиків, що складається з граміцидину і тироцидину; це стало стимулом для інших учених, що знайшли ще більш важливі для клініки антибіотики. У 1942 Х.Флори зі своїми колегами по Оксфордскому університету повторно досліджував пеніцилін і довів можливість його клінічного використання як нетоксичного засобу лікування багатьох гострих інфекцій. Тоді ж ці речовини почали називати антибіотиками. З.Ваксман зі своїми студентами в Університеті Ратджерса, США, займався актиноміцетами (такими, як Streptomyces) і в 1944 відкрив стрептоміцин, ефективний засіб лікування туберкульозу й інших захворювань. Після 1940 була отримана велика кількість клінічно важливих антибіотиків, у їх числі бацитрацин, хлорамфенікол (левоміцетин), хлортетрациклін, окситетрациклін, амфотерицин В, циклосерин, еритроміцин, гризеофульвін, канамицин, неоміцин, нистатін, полімиксин, ванкоміцин, віоміцин, цефалоспорини, ампіцилін, карбеніцилін, аміноглікозиди, стрептоміцин, гентамицин. В даний час відкривають все нові і нові антибіотики. У середині 1980-х років у США антибіотики прописувалися частіше, ніж будь-які інші ліки, за винятком седативних засобів і транквілізаторів.
В одних випадках під впливом антагоністів мікроби перестають рости і розмножуватися, в інші - клітини їх лізуються, розчиняються, у третіх - гальмуються або зупиняються біохімічні процеси усередині клітин, наприклад дихання, синтез амінокислот. Найбільш різко антагонізм виявляється в актиноміцетів, бактерій і грибів. Синьогнойна паличка активно пригнічує паличку чуми; актиноміцети, що виділяють нистатин, пригнічують ріст дріжджових організмів.
1 .2 Основні види антогонізму
Антагонізм 1 (греч. antagonіsma боротьба, суперництво) речовин - і вид взаємодії речовин (амінокислот, вітамінів, лікарських речовин) в організмі, що характеризується тим, що однин з них послабляє дію іншого.
Антагонізм абсолютний - антагонізм, при якому ефект спільної дії речовин менше, ніж ефект кожного з них, що діють порізно.
Антагонізм двосторонній – антагонізм, при якому кожна з двох речовин послабляє або знімає дію іншої.
Антагонізм конкурентний - антагонізм прямої дії, при якому речовини оборотно взаємодіють з тими самими рецепторами клітин.
Антагонізм неконкурентний - антагонізм, при якому одна з взаємодіючих речовин діє на рецептор поза його активним центром.
Антагонізм непрямий - антагонізм, при якому дія речовин спрямована на різні клітинні елементи.
Антагонізм нерівноважний - антагонізм, при якому одна з речовин взаємодіє з рецепторами необратимо.
Антагонізм однобічний - антагонізм, при якому дія однієї речовини знімає дія іншої, але не навпаки.
Антагонізм відносний - антагонізм, при якому ефект спільної дії речовин більший, ніж окремі ефекти кожного з них, але менше суми ефектів тих же речовин, що діють порізно.
Антагонізм спрямований - антагонізм, при якому дія речовин спрямована на ті самі клітинні елементи.
Антагонізм 2 мікробів - тип взаємин між мікроорганізмами, що характеризується тим, що при спільному існуванні мікроорганізми одного виду пригнічують життєдіяльність інших мікроорганізмів.
Антагонізм 3 функціональний - умовна протилежність функцій органів або систем організму, що беруть участь в одночасній сполученій діяльності.
1 .3 Антагонізм у світі мікробів
З явищем антагонізму у світі мікробів було зв'язане відкриття антибіотиків.
Антагонізм широко розповсюджений у природних мікробних популяціях, що складаються з бактерій, грибів, актиноміцетів, дріжджів, водоростей, найпростіших і інших мікроорганізмів. Значне поняття антагонізму включає і такі форми взаємин, як конкуренція, хижацтво, паразитизм. Нас у даному випадку цікавить антагонізм у вузькому змісті, тобто антагонізм, обумовлений утворенням антимікробних речовин і, зокрема, антибіотиків. Взаємини, обумовлені продукцією будь-яких антимікробних речовин, можна назвати активним або прямим антагонізмом. На відміну від його існує пасивний, або непрямий, антагонізм, при якому придушення одних мікроорганізмів відбувається за рахунок зміни іншими мікробами умов навколишнього середовища в несприятливу для розвитку сторону. Антагонізм може бути однобічним (мікроорганізм придушує розвиток свого конкурента, не реагуючи на вплив суперника) і двостороннім (відбувається взаємне гноблення мікроорганізмів у співтоваристві). Існує ще поняття спрямованого (насильницького), або змушеного, антагонізму. За цих взаємин спостерігається утворення антимікробних речовин (імовірно, різної природи, що володіють різним механізмом дії) тільки при спільному вирощуванні двох різних мікроорганізмів, що в умовах ізольованого культивування цих речовин не утворюють. Антагонізм між мікроорганізмами можна спостерігати й у лабораторних умовах. Активність продуцентів антибіотиків звичайно виражають масою антибіотика, що міститься в одиниці об'єму поживного середовища в якій вирощували продуцент.

Рис. 1. Синергізм у мікробів. Навколо агарового блоку з культурою актиномпцета видна зона стимуляції росту цвілевого гриба.
Термін "антибіотики", або "антибіотичні речовини", запропонований у 1942 р. Ваксманом, спочатку позначав хімічні сполуки, утворені мікроорганізмами, що мають здатність пригнічувати ріст і навіть руйнувати бактерії й інші мікроорганізми. Це визначення, як виявилося згодом, не зовсім точне, тому що в число антибіотиків потрібно було б уключити речовини мікробного походження, що спричиняють не специфічну, а загальну антисептичну або консервативну дію, на живі клітини. До таких речовин відносяться, зокрема, спирти, органічні кислоти, перекиси, смоли й ін. До того ж антибактеріальна дія цих сполук виявляється тільки у відносно високих концентраціях. До антибіотиків варто відносити тільки такі речовини, що у певних кількостях виявляють специфічну (вибіркову) дію на окремі ланки обміну речовин мікробної клітини. Пізніше в тканинах вищих рослин і тварин були знайдені сполуки, здатні в малих кількостях специфічно пригнічувати ріст мікробів. Більш того, було показано, що деякі подібні антибіотики (наприклад, цитринін) можуть синтезуватися як мікробами, так і вищими рослинами. Таким чином, коло організмів-продуцентів антибіотичних речовин розширився, що також повинно було знайти відображення в терміну "антибіотики". Установлення структури молекул багатьох антибіотиків дозволило здійснити хімічний синтез ряду цих сполук без участі організмів-продуцентів.

Рис. 2. Приклад антагонізму в мікробів. Видна зона придушення росту стафілококу навколо агарового блоку з культурою актиноміцету.
Подальший етап розвитку хімії антибіотиків - зміна (трансформація) молекул цих сполукдля одержання похідних, що володіють рядомпереваг у порівнянні з вихідними препаратами. Такий напрямок досліджень пояснюється в основному двома причинами: необхідністю зниження токсичності антибіотиків при збереженні їх антибактеріальної дії; боротьбою з інфекційними захворюваннями, викликуваними стійкими до широко застосовувалися антибіотикам формами патогенних мікроорганізмів. Переваги похідних антибіотиків у порівнянні з вихідними виявляються також і в зміні розчинності, подовженні терміну циркуляції в організмі хворого і т.д..
Одержати похідні антибіотиків можна за допомогою як хімічного, так і біологічного синтезу. Відомий і комбінований спосіб одержання препаратів. У цьому випадку ядро молекули антибіотика формується при біосинтезі за допомогою відповідних мікроорганізмів-продуцентів, а "добудування" молекули здійснюється методом хімічного синтезу. Отримані цим способом антибіотики називаються напівсинтетичними. Так були отримані і знайшли широке застосування в клініці досить ефективні напівсинтетичні пеніциліни (метицилін, оксацилін, ампіцилін, карбеніцилін) і цефалоспорини (цефалотин, цефалоридин) з новими в порівнянні з природними антибіотиками цінними терапевтичними властивостями.
Усі ці дані, накопичені в процесі становлення і розвитку науки про антибіотики, потребували уточнення терміна "антибіотики". В даний час антибіотиками варто називати хімічні сполуки, утворені різними мікроорганізмами в процесі їх життєдіяльності, а також похідні цих сполук, що володіють здатністю в незначних концентраціях вибірково пригнічувати ріст мікроорганізмів або викликати їх загибель. Цілком імовірно, що і це формулювання з подальшим прогресом антибіотичної науки буде уточнюватися.
В перші роки після відкриття антибіотиків їх одержували з використанням методу поверхневої ферментації. Цей метод полягав у тому, що продуцент вирощували на поверхні поживного середовища у плоских суліях (матрацах). Щоб одержати помітні кількості антибіотика, були потрібні тисячі матраців, кожний з яких після зливу культуральної рідини необхідно було мити, стерилізувати, заповнювати свіжим середовищем, засівати продуцентом і інкубувати у термостатах. Малопродуктивний спосіб поверхневої ферментації (поверхневого біосинтезу) не міг задовольнити потреб в антибіотиках. У зв'язку з цим був розроблений новий високопродуктивний метод глибинного культивування (глибинної ферментації) мікроорганізмів - продуцентів антибіотиків. Це дозволило в короткий термін створити і розвити нову галузь промисловості, що випускає антибіотики у великих кількостях.
Метод глибинного культивування відрізняється від попередніх тим, що мікроорганізми-продуценти вирощують не на поверхні поживного середовища, а у всій її товщі. Вирощування продуцентів ведуть у спеціальних чанах (ферментаторах), ємність яких може перевищувати 50 м3 . Ферментаторимають пристосування для продування повітря через поживне середовище і мішалками. Розвиток мікроорганізмів-продуцентів у ферментаторах відбувається при безперервному перемішуванні живильного і середовища подачі кисню (повітря). При глибинному вирощуванні в багато разів у порівнянні з вирощуванням продуцента на поверхні середовища збільшується нагромадження біомаси (з розрахунку на одиниця об'єму поживного) середовища, а виходить, і зростає вміст антибіотика в кожному мілілітрі культуральної рідини, тобто підвищується її антибіотична активність.
Виробнича схема біосинтезу будь-яких антибіотиків включає наступні основні стадії: ферментацію, виділення антибіотика і його хімічне очищення, сушіння антибіотика і приготування лікарської форми. Для здійснення ферментації - біохімічного процесу переробки сировини - необхідно мати поживне (середовище, сировина) і мікроорганізми, що переробляють цю сировина. Підняттю продуктивності антибіотичної промисловості, крім впровадження в практику глибинної ферментації, у значному ступені сприяло використання для біосинтезу нових високопродуктивних штамів-продуцентів. Для їх одержання були розроблені спеціальні методи селекції. Унаслідок великої варіабельності продуцентів і швидкої втрати ними вихідних властивостей (особливо рівня антибіотичної активності) необхідно було розробити методи збереження продуцентів і підтримки активності, а також способи приготування посівного матеріалу для засівання величезних обсягів поживного середовища у ферментерах.
Бактерії й актиноміцети - продуценти антибіотиків
Серед бактерій найбільш часте явище антагонізму зустрічається в спороносних паличок, що належать до роду Bacіllus (В. subtіlіs, Вас. mesenterіcus, В. brevіs, В. polymyxa і ін.), і неспороносних з роду Pseudomonas (P. fluorescens і ін.). З культури неспороносної бактерії антибактеріальна речовина піоціаназа була виділена Р. Еммеріхом і О. Лоу наприкінці минулого століття. Пізніше були виявлені антибіотичні речовини в культурах молочнокислих стрептококів, мікрококів, азотобактера й ін. Як приклад можна назвати кілька антибіотиків, утворених різними бактеріями:
| Організм-продуцент | Антибіотик |
| Bacіllus brevіs | грамицидин і тироцидин |
| Bac і llus brev і s var. G.-B. | грамицидин 3 |
| Bac і llus subt і l і s , Вас. mesenter і cus | субтплин, бацитрацин |
| Bac і llus polymyxa | полимиксин |
| Pseudomonas pyocyanea | пиоцианин |
| Streptococcus lact і s | низин |
Самою багатої антагоністами групою ґрунтових мікроорганізмів виявилася група променистих грибків, актиноміцетів, а серед них - представники роду Actіnomyces . Переважна більшість антибіотиків, що знайшли застосування в медицині і народному господарстві, отримано саме з цієї групи мікроорганізмів.
Численними роботами дослідників установлено, що актиноміцети-антагоністи зустрічаються в різних природних субстратах, але більше всього їх у ґрунті (до декількох мільйонів у 1 г). У деяких ґрунтах можна знайти порівняно невелику кількість актиноміцетів, але майже усі вони виявляються антагоністами. Установлено, що в окультурених, добре угноєних ґрунтах зустрічається більше актиноміцетів-антагоністів, ніж у ґрунтах цілинною, бідних органічною речовиною, малородючих ґрунтах. Багато антагоністів було виявлено Н. А. Красильниковим у ґрунтах південних посушливих районів. Крім кліматичних і географічних умов, на вміст актиноміцетів-антагоністів у ґрунтах впливають також сезонність, рослинний покрив, мікробне населення, вологість, кислотність і тип ґрунту, забезпечення її киснем і багато інших факторів.
1.4 Механізм мікробного антагонізму
Механізми мікробного антагонізму різні. Механізм антагонізму різний і в багатьох випадках не зрозумілий. Найчастіше антагоністи діють на конкурентів продуктами обміну речовин, у тому числі антибіотиків, або витісняють їх унаслідок більш інтенсивного розмноження або переважно споживання їжі. Ще в 19 ст. неодноразово намагалися використовувати явище антагонізму для лікування хвороб, викликаних бактеріями, але не мали успіху, тому що працювали з неочищеними препаратами. Мікроби-антагоністи широко використовуються у виробництві антибіотиків.
Вони можуть бути зв'язані з конкуренцією за кисень і поживні речовини, зі зміною рН середовища убік, несприятливий для конкурента, і т.д. Одним з універсальних механізмів мікробного антагонізму є синтез хімічних речовин-антибіотиків, що пригнічують ріст і розмноження інших видів мікроорганізмів (бактеріостатична дія), або вбивають їх (бактерицидна дія).
Розділ 2 Антибіотики та їх використання
2.1 Роль антибіотиків у біоценозах
Однієї з характерних рис антибіотиків є вибірковість дії - кожен антибіотик діє на визначений набір видів мікроорганізмів, тобто має свій специфічний антимікробний спектр дії. Наприклад, актиноміцети, що належать до виду Act і nomyces streptomyc і n , пригнічують ріст грампозитивних і грамнегативних бактерій, мікобактерій, деяких видів дріжджів і грибів. Act і nomyces levor і s не пригнічує ріст бактерій, але пригнічує розвиток дріжджів, деяких дріжжоподібних організмів, міцеліальних грибів і т.д. Антимікробний спектр дії - один з таксономічних ознак у систематику актиноміцетів, що служать для розмежування видів. Вироблювані актиноміцетом антибіотики не пригнічують розвитку власної культури навіть у концентраціях, що у багато разів перевищують мінімальну концентрацію, яка пригнічує ріст інших мікроорганізмів.
Багато учених вважають, що здатність синтезувати антибіотики - корисне для виду пристосування, що виробилося і закріплене в процесі еволюції організмів. Продукування антибіотиків - один з факторів, що дає певні переваги мікроорганізму-антагоністу в боротьбі за існування в складних природних мікробних асоціаціях. Відповідно до іншої точки зору, антибіотики являють собою "елементи" обміну речовин у мікроорганізму, які не відіграють пристосувальної, еволюційної ролі. Ця точка зору розділяється З. Ваксманом, X. Лешевалье і деякими іншими закордонними дослідниками. Своє трактування вони обґрунтовують головним чином так, що, по-перше, антибіотики утворюються не всіма широко розповсюдженими мікробами; по-друге, антибіотики швидко інактивуються в ґрунті. Але продукування антибіотиків - лише одне з пристосувань, вироблене мікробами в боротьбі за існування. Антагонізм мікробів може обумовлюватися і рядом інших речовин, крім антибіотиків, а також пристосувальними механізмами, не зв'язаними з утворенням хімічних сполук. Усе це також може сприяти широкому поширенню мікробів, у яких не виявлена здатність синтезувати антибіотики. До цього ж варто додати, що в лабораторних умовах, коли той або інший актиноміцет вирощують ізольованно (поза природним мікробним співтовариством) на штучних поживних середовищах не завжди вдається виявити здатність до синтезу антибіотика. Тобто неактивні в лабораторних умовах штами актиноміцетів здатні до біосинтезу антибіотиків.
Що стосується другого доводу, то в літературі є численні дані, що свідчать про наявність антагонізму між мікробами в ґрунті, обумовленого виділенням антибіотиків. Ці дані підтверджені лабораторними досвідами на чистих культурах мікроорганізмів і перевірені в польових умовах. У мікрозонах, де є присутнім антибіотик (у ґрунті), він безумовно впливає на мікроби, що контактують з ним. Дійсно, у ґрунті відбувається процес руйнування антибіотиків як під впливом різних фізико-хімічних факторів (рН, наявність колоїдів і ін.), так і в результаті інактивації специфічними речовинами (ферментами), утвореними мікробами. Однак це не може бути доказом відсутності дії антибіотиків на мікроби в ґрунті. Інактивація антибіотиків мікроорганізмами - природна реакція живого організму на шкідливий вплив середовища.
У відповідь на вплив антибіотиків мікроорганізми виробляють різні форми захисту. У будь-якому випадку остаточний результат цієї взаємодії буде визначатися цілим рядом і таких факторів, як швидкість розмноження, інтенсивність утворення антибіотиків і інактивуючих речовин, здатність повніше використовувати речовини навколишнього середовища для життєдіяльності, ступінь стійкості до несприятливих фізико-хімічних умов існування і т.д.
Рис. 3. Колонії актиноміцетів, що утворюють антибіотики, на поверхні агаризованих поживних середовищ
Таким чином, антибіотики не можуть вважатися випадковими елементами обміну речовин мікробної клітини, не граючої пристосувальної ролі в боротьбі за існування.
2.2 Поняття про антибіотики
Антибіотики (лат. anti — проти і bios — життя) — це речовини мікробного, рослинного й тваринного походження, котрі мають високу протимікробну активність, в основі якої лежить принцип антагонізму. Антибіотики широко застосовують у медицині, а також у різних галузях народного господарства.
Ще в давні часи індіанці племені майя застосовували плісняву для лікування при ранах і захворюваннях кишок. У середні віки Ібн-Сіпа використовував плісняву при гнійних ранах. У 187t-p. терапевт В. О. Манассеїн відкрив пригнічення зеленою пліснявою мікроорганізмів у живильному середовищі Пастера, а дерматолог О. Г. Полотебнов застосував емульсію цієї плісняви для лікування при виразках та гнійних ранах. У 1877 р. у дисертації Н. В. Лебединськин вказав, що продукти, які запліснявіли, зменшу ють кількість мікроорганізмів у кишках. В 1877 р. Луї Пастер та Жубер відкрили принцип антагонізму мікроорганізмів, установивши загибель бацили сибірки в суміші з гноєтворною флорою. На основі вчення Л. Пастера про антагонізм мікроорганізмів 1. І. Мечніков показав, що культура молочнокислих бактерій гальмує розвиток гноєтворної флори кишок. У 1928 р. англійський вчений О. Флемінг відкрив антибіотик пеніцилін із плісняви Penicillium nodosum , очищений препарат якого було отримано у 1940 р. американськими вченими X. В. Флорі та Е. Б. Чейном. У Росії в 1942 р. пеніцилін було отримано із плісняви Penicillium crustosum З. В. Єрмольєвою, яка також налагодила його промисловий випуск. Виділення стрептоміцину із променистого гриба у 1944 р. пов'язано з ім'ям американського вченого З. Ваксмана.
Починаючи від зоолога Б. П. Токіна (1928), вчені займаються також речовинами рослинного походження — фітонцидами, які мають антибактеріальну дію. Сьогодні відомо понад 2000 препаратів антибіотиків.
Антибіотики класифікують за різними ознаками. За походженням:
1. Плісняві гриби (пеніциліни, цефалоридини та ін.).
2. Променисті гриби (стрептоміцин, левоміцетин, тетрациклін).
3. Бактерії (граміцидин).
4. Рослини (новоіманін).
За хімічним складом:
1. релактамні (група пеніциліну, цефалоспорину, монобактами, карбапенеми).
2. Антибіотики-макроліди і азаліди (еритроміцин, олеандоміцину фосфат, спіраміцин, рокситроміцин, азитроміцин, клари-троміцин).
3. Група тетрацикліну (тетрацикліну гідрохлорид, метацикліну гідрохлорид, доксицикліну гідрохлорид).
4. Група левоміцетину (левоміцетин, левоміцетину стеарат, левоміцетину сукцинат).
5. Аміноглікозиди (стрептоміцину, нео-міцину, гентаміцину сульфат, канаміцин, мономіцин, амікоцину сульфат, тобраміцин, сизоміцину сульфат).
6. Поліпептиди (граміцидин С, полімік-сини,бацитрацин).
7. Глікопептиди (ванкоміцин, ристомі-цин).
8. Полієни (амфотерицин, амфоглюка-мін, ністатин, леворин).
9. Анзаміцини (рифампіцин, рифаміцин).
10. Похідні кислоти аурелової (олівоміцин, мітоміцин).
11.Препарати стероїдної структури (фузидин-натрій).
12. Лінкозаміди (лінкоміцину гідрохлорид).
13. Похідні антрацикліну (рубоміцину, доксорубіцину, ідарубіцину гідрохлорид).
14. Антибіотики різних груп (фузафунгін).
За спектром протимікробної дії:
1. Переважно на грампозитивні бактерії (пеніциліни, макроліди).
2. Переважно на грамнегативні бактерії (поліміксини).
3.Широкого спектра дії (тетрацикліни, левоміцетини; напівсинтетичні пеніциліни — ампіцилін та ін., цефалоспорини, аміноглікозиди, напівсинтетичні макроліди, азаліди — рокситроміцин, азтреонам та ін.).
4. Вибіркової дії:
а) протимікозні (ністатин, леворин, амфотерицин, гризеофульвін та ін.);
б) протипухлинні (рубоміцину гідрохлорид, блеоміцин).
За переважним механізмом дії:
1. Порушують синтез оболонки мікробної клітини:
а) блокують активність ферментів: транспептидази, карбоксипептидази, що призводить до припинення полімеризації пептидоглікану;
б) гальмують входження в мономерипептидоглікану одного із елементів (ристоміцину сульфат, ванкоміцин).
2. Порушують функцію клітинної оболонки (мембрани):
а) взаємодіють із білково-ліпідними комплексами, викликають дезорганізаціюструктури (ністатин, амфотерицин);
б) порушують проникність низькомолекулярних речовин (поліміксин).
3. Порушують синтез білка (тетрацикліни, левоміцетини).
4. Порушують синтез нуклеїнових кислот:
а) порушують синтез РНК на рівні РНК-полімерази (рифампіцин, рифаміцин);
б) порушують синтез ДНК на рівні ДНК-матриці (рубоміцину гідрохлорид, брунеоміцин).
5. Пригнічують тканинне дихання мікроорганізмів (кислота уснінова).
2.3 Дія антибіотиків на мікроорганізми
Бактеріостатична дія: Порушення синтезу білка в середині клітини і тому затримується ріст і розвиток мікроорганізмів. (Тетрацикліни, левоміцетини, макроліти, аміноглікозиди). Аміноглікозиди і левоміцетини на деякі мікроорганізми діють бактерицидно.
Чому при введенні в організм антибіотики проявляють перш за все протимікробну дію (т.б. діють на клітини мікробів). Справа в різниці інтенсивності поділу і життєдіяльності мікроорганізмів і клітин нашого організму. В середині організму мікроби розмножуються швидше, а антибіотики діють на клітини, які швидко розмножуються, тому в цих умовах антибіотики в першу чергу діють на мікроорганізми, а вже потім (при більш тривалій дії) на клітини нашого організму. Небезпека антибіотиків більша у дитячому віці (поділ клітин швидкий), вона знижується із збільшенням віку. Справа в тому, що збільшенням віку інтенсивність обміну і поділу клітин в організмі падає.
Але мікроорганізми гинуть не всі і зразу. Спори мікроорганізмів в присутності антибіотиків зберігають життєдіяльність (інтенсивність розмноження знижена, повністю відсутнє ділення і тимчасова зупинка життєдіяльності).
Антибіотики поступово сповільнюють розмноження мікроорганізмів, т.б. в організмі вони поступово вироджуються. Причому цей процес далеко не завжди закінчується повним вимиранням колоній бактерій. Справа в тому, що вони мінливі і швидко присовуються до змінених умов. В зв’язку з цим в присутності антибіотиків мікроби здатні давати потомство із покоління в покоління мікроорганізмів, і дуже швидко всі мікроби можуть стати не чутливими до препарату, особливо коли не дотримуватись принципів хіміотерапії.
Як правило, в організмі людини для проявлення протимікробної дії антибіотика потрібна постійна безперервна дія на протязі декількох діб. Тривала дія на організм людини може привести до пригнічення росту клітин організму, які швидко діляться. Такими є клітини крові червоний кістковий мозок. Інтенсивність їх поділу менша, ніж у мікробів, тому, Щоб антибіотики діяли, потрібний більше тривалий час (тижні). В червоному кістковому мозку антибіотики пригнічують утворення лейкоцитів і еритроцитів (частина лейкоцитів живе більше тижня, а еритроцити живуть біля 4-х місяців), і друге – подібністю лейкоцитів по своїй форм і життєдіяльності до бактерій.
Отже, при тривалій дії антибіотиків на організм людини зменшується кількість лейкоцитів в організмі. Тому тривале застосування антибіотиків зменшує захисні сили організму (послаблюється в боротьбі організму до інфекцій). Значення захисних сил нашого організму в боротьбі з інформаціями дуже велике. Їх ефективність всередині організму набагато більша протимікробної активності самого сильного антибіотику. Це легкого перевірити на прикладі лікування СНІДу. Хворі СНІДом в результаті дії вірусу втрачають активність захисних сил і гинуть не від вірусу СНІДом, не дивлячись на насичення його тіла самими сучасними і сильними антибіотиками. Інакше, кажучи, антибіотики . Інакше кажучи, антибіотики в боротьбі з інфекцією у відсутності захисних сил організму дуже слабкі союзники. Антибіотики лише допомагають нашим захисним силам в боротьбі з інфекціями, які не в силі справитись з ними самостійно. Найбільш виражено пригнічення кровотворення (лейкопеніз) у левоміцетинів.
Антибіотиків є багато. всі вони розрізняються по спектру дії або по хімічній будові. І звичайно потрібно враховувати їх небезпеку для організму. Найменш токсичними є пеніциліни, а потім цефалоспорини.
- Пеніциліни можуть викликати алергічні реакції.
- Цефалоспорини: порушення функції нирок, дисбактеріоз, диспепсичні розлади, при в/в можуть виникати тромбофлебіти.
В групу пеніцилінів входять слідуючи антибіотики. Відмінність:
- Бензилпеніцилін – натрію, калію, феноксиметилпеніцилін, біцилін, ампецилін, метицилін, оксацилін, ампіокс, ампіцилін, карбеніцилін та ін.
Всі вони близькі по принципу дії на наш організм і мікроорганізми, найменш токсичні. Відрізняються вони по швидкості заступлення ефекту, тривалості дії, ефективності при різних шляхах введення, здатності накопичуватись в окремих органах і тканинах, а також по активності по відношенню до деяких мікробів.
Пеніциліни поділяються на природні і напівсинтетичні.
Природні пеніциліни діють лише на деякі мікроорганізми – в основному на грам позитивні (стрептококи, стафілококи, пневмококи), збудників дифтерії, сибірської виразки, сифілісу, н деякі грам негативні (гонококи, менінгококи), Не ефективні у відношенні вірусів, грибків, найпростіших (амеби, трихомонади), туберкульозної палички, збудників дизентерії, холери, черевного тифу, сипного тифу. Тому ці антибіотики відносяться до вузького спектру дії.
Серед пеніцилінів більш широкий спектр дії мають ампіцилін, карбеніцилін, ампіокс, мікроцид. Активні у відношенні грам негативних мікроорганізмів і збудників дизентерії, кишенчної палички. Пеніциліни погано проникають у головний мозок (мало ефективні при лікуванні менінгіту).
Вирішуючи питання про вибір препарату, керуються слідуючим. Пеніциліни широкого спектру дії використовують в тих випадках, коли хвороба викликається змішаною інфекцією, або збудник захворювання не виявлений. В усіх інших випадках (коли тип збудника і його чутливість до пеніциліну визначені) використовують пеніциліни вузького спектру дії. Пеніциліни широкого спектру дії, як і всі антибіотики широкої дії порушують орисну мікрофлору ШКТ. Може розвинуться інфекційне пораження системи травлення (кандидомікоз). Для профілактики використовують – леворин, ністатин.
Небажана дія – алергія. Хворим, які страждають алергією ці препарати вводити не можна. Бензилпеніцилін – натрі, калію – однотипні, але відрізняються по впливу на організм. Найменш небезпечна натрієва сіль. Її вводять різними шляхами в/м, в/в/, ендолюмбально. Калієва сіль – більш небезпечна. Підвищена концентрація іонів калію в крові, вище норми, може сповільнити роботу серця і навіть зупинити його роботу. Тому цей препарат не слідує вводити в/в. Він звужує кровоносні судини в місці знаходження препарату, викликаючи їх спазм. Це супроводжується біллю в місці ін’єкції. Ці препарати швидкої і короткочасної дії (дія триває 4 години).
Менш розчинні і більш триваліше діють в організмі – біциліни. Суспензії цих препаратів водять в/м, Біцилін-1, 1 раз на тиждень по 600000 ДО або 1р. в два тижні по 120000 ОД. Біцилін-3 вводять гідні для тривалого підтримання концентрації антибіотика в організмі. Це використовують при лікуванні і профілактики ревматизму ( в осінньо-весняний період) і сифілісу.
І, на кінець, феноксиметилпеніцилін випускається в таблетках для прийому всередину. Приймають його 4-6 р. на добу. Використовують в тих випадках, коли ін’єкції інших препаратів пеніцилінів неможливі, а інфекційний процес не носить загрози для життя.
Частіше при слабкому протимікробному ефекті пеніцилінів їх заміняють цефалоспоринами. При виборі препарату враховують не тільки спектр дії антибіотиків, але враховують чутливість збудника до препарату. Спектр протимікробної дії цефплоспоринів майже такий самий, як у пеніцилінів широкого спектру дії. Дія їх триває 6-8 год. Більшість цефалоспоринів вводять ін’єкційно 2-4 рази на добу. При тривалому прийомі цих препаратів може порушуватись функція нирок, зменшуються імунні властивості організму (лейкопенія), викликають дисбактеріоз.
Інші антибіотики, ще більш небезпечні. Антибіотики – аміноглікозиди (стрептоміцину сульфат, неоміцин у сульфат, канаміцин, гентаміцин, тоброміцин, сизоміцин) здатні викликати ускладнення при звичайному (а не тривалому) курсі прийому. При цьому можуть викликати пораження нирок, органів слухі нервової системи і вестибулярного апарату. Особливо токсичні для дітей. Достатньо 5-7 днів регулярного прийому цих ліків на організм дитини, як вона назавжди може позбавитись слуху. Ці препарати діють ще на туберкульозну паличку, синьо гнійну і збудників дизентерії. Дія триває в основному 8 год.
Стафілококи –і інші грам негативні мікроорганізми стійкі до пеніциліну, стрептоміцину, тетрацикліну зберігають чутливість до макролітів, тому ці препарати використовують як резервні чутливості до пеніцилінів і цефалоспоринів. Макроліти малоефективні для монотерапії, так як до них швидко виробляються стійкі форми збудників, тому ті застосовують в період долікування або при комбінованій терапії у хворих з важкопротікаючою інфекцією.
Роблячи висновок, можна сказати, що всі антибіотики небезпечні для нашого організму; в ньому вони пошкоджують тканини з інтенсивним білковим обміном і клітини, які розмножуються швидким поділом. Найбільш пошкоджуються тканини зародку, площа і дитини. В організмі дорослої людини антибіотики пошкоджують червоний кістковий мозок, деякі структури нервової системи. Небезпечні наслідки прийому антибіотиків найчастіше виникають лише після багатоденного регулярного їх прийому і не проявляються в перші 4-5 днів. Токсична дія найбільш проявляється лише після 5-7 днів і збільшується з продовження курсу і збільшенням доз антибіотиків.
Не всі антибіотики однаково небезпечні для нас. Найменш токсичні – пеніциліни, більш токсичні антибіотики широкого спектру дії, середня токсичність у цефалоспоринів.
Повернемось до позитивної дії антибіотиків.
Пеніциліни використовують при гнійних інфекціях шкіри, слизових оболонок, росистому запаленні, ангіні, дифтерії, скарлатині, пневмонії, плевріті, ендокардуті, перитоніті, сепсисі, менінгіті, гнійному запаленні захворювання вуха, горла, очей, носа, сечостатевої систем та ін. За допомогою пеніцилінів можна лікувати різні інфекції хвороби, але не завжди вони допомагають. За роки застосування пеніцилінів багато мікроорганізмів привикли до цієї групи препаратів. Тому ефективність пеніцилінотерапії зараз нижча, ніж в перші роки застосування і все знижується. Позитивні ефекти вдається підтримувати високими дозами.
Самий широкий спектр дії у тетрациклінів. Вони діють на всі бактерії (грам позитивні і грам негативні), збудника сифілісу, рикетсії, а також на частину найпростіших (на амеб і збудників дизентерії), крупні віруси (віруси трахоми). Не діють на синьо гнійну паличку, грибки, дрібні віруси (група, крові, поліомієліта), туберкульозу паличку.
Цифалоспорини і макроліти ближче стоять до пеніцилінів, інші до тетрациклінів. Такі антибіотики як канаміцин, стрептоміцин ефективні по відношенню до туберкульозної палички і протея.
Група антибіотиків вузького спектру дії, які діють на грам негативні мікроорганізми – це полі міксини. Вони ефективні по відношенню до кишечної, синьо гнійної і дизентерійної палички і черевного тифу, паратифу.
Механізм дії антибіотиків складний, вони порушують різні сторони метаболізму. Так, стрептоміцин порушує окремі фази вуглеводного обміну; левоміцетин пригнічує активність ферментів типу естераз; тетрациклін вступає у процеси комплексоутворення з йонами магнію та кальцію.
У деяких антибіотиків переважає бактерицидна дія — пеніциліни, аміноглікозиди; у інших — бактеріостатична — тетрацикліни, левоміцетин, макроліди.
2.4 Основні вимоги до антибіотиків
Вимоги, пропоновані до антибіотиків. Щоб бути гарним лікувальним засобом, антибіотик повинний мати, принаймні, деякі обов'язкові властивості.
1. При низької концентрації (10-30 мкг /мл) він повинен убивати збудника хвороби або пригнічувати його ріст і розмноження.
2. Активність антибіотика не повинна істотно знижуватися під дією рідин організму.
3. Він повинен швидко впливати на мікроорганізм, щоб за короткий термін перервати його життєвий цикл.
4. Антибіотик не повинен шкодити макроорганізму. Алергенність і токсичність і після введення разової дози, і після багаторазового введення повинні бути відсутні.
5. Антибіотик не повинен перешкоджати процесу видужання.
6. Антибіотик не повинен знижувати і тим більше пригнічувати імунологічні реакції. Він не повинен наносити ніякого збитку імунній системі організму.
Хоча, тут є і виключення. Мова йде про пошук таких антибіотиків, які б пригнічували трансплантаційний імунітет. До числа останніх відноситься циклоспорин А, що володіє могутньою імуносупресивною дією. Однак його широкому застосуванню перешкоджає цитотоксичній діє на нирки.
Особливості застосування антибіотиків у сучасних умовах та засади раціональної антибіотико терапії.
Раціональне застосування антибіотиків у лікуванні госпітальних та поза лікарняних інфекційних захворювань потребує урахування багатьох факторів, пов’язаних як з пацієнтом та збудником інфекції, так і з соціальними аспектами. У статті розглянуто можливі причини необґрунтованого призначення антибіотиків на сучасному етапі, наведено характеристику найбільш вживаних та перспективних груп антибактеріальних засобів, а також основні правила проведення раціональної антибіотикотерапії та напрямки пошуку нових препаратів.
Одним із завдань оптимізації антибіотикотерапії є скорочення її тривалості. Якщо антибіотик призначений вірно, то позитивна динаміка, хоча б щодо окремих показників, помітна вже на 3-ю добу. А через 7–10 днів етіотропну терапію інфекційно-запального процесу можна закінчувати. Якщо ж динаміки на 3-ю добу немає, то необхідна корекція терапії. Її слід проводити з урахуванням бактеріологічних даних. Ефективність другого курсу знову оцінюється на 3-ю добу, і за позитивної клінічної відповіді він триває 7–10 днів. При адекватному виборі засобів потреба у третій зміні антибіотиків виникає рідко. Отже, тривалість раціонального курсу антибіотикотерапії складає у переважній більшості випадків 10 днів при вдалому стартовому лікуванні та збільшується до 13 при необхідності заміни препарату (за бактеріального ендокардиту ефективність антибіотика оцінюється трохи пізніше — на 5–6 добу, а терапія подовжується. При ряді інших захворювань, зокрема хронічних остеомієлітах, терміни лікування також зміщуються).
В окремих випадках із тривалістю протимікробної терапії пов’язане ще одне питання, і виникає воно, як не дивно, при успішному лікуванні. Трапляється, що лікар не наважується на 10-у добу відмінити антибіотик внаслідок залишкових явищ інфекції. Чи слід змінювати препарат, який вже вводився 10 днів, чи довести лікування до одужання тим самим засобом?
У відповідь на це питання в науковій літературі існують розрахунки динаміки розповсюдження субпопуляцій резистентних штамів збудників, якими і треба користуватись у даному випадку. Проте слід зазначити, що інколи терапія може бути подовжена тим самим препаратом до 12–14 днів без будь-яких негативних наслідків. Необхідно лише пам’ятати, що подібне подовження лікування (понад10 діб) не є бажаним для рифампіцину, стрептоміцину та лінкозамінів (лінкоміцин, кліндаміцин), оскільки до даних препаратів мікроорганізми набувають стійкості шляхомодноступеневих мутацій.
Розглядаючи питання раціонального застосування антибактеріальних препаратів, доцільно зупинитися на характеристиці окремих, найбільш уживаних та перспективних на сьогоднішній день груп засобів. При порівнянні антибіотиків, що використовуються в Україні та світі, можна зазначити низку відмінностей. У нашій країні зберігає свої позиції традиційне лікування пеніцилінами, що займають майже третину всього продажу антибіотиків — 36 %. Після них на українському ринку йдуть аміноглікозиди та сульфаніламіди (разом з триметопримом) — по 15 %. І тільки близько 7–8 % припадає на цефалоспорини, макроліди, тетрацикліни. Останнім часом як на Заході, так і в Україні стрімко зростає об’єм використання фторхінолонів та фунгіцидних засобів. Характерною особливістю останнього десятиріччя є зменшення в антибактеріальній терапії частки тетрациклінів (4,8 %), але в Україні вони залишаються досить популярними препаратами.
Висновки
Антагонізм мікробний - пригнічення життєдіяльності одного мікроба іншим. Одна з форм взаємин мікробів в асоціаціях. Є принциповою основою одержання і застосування антибіотиків. Існує декілька видів антогонізму: активним або прямим антагонізм, пасивний, або непрямий, антагонізм, антагонізм може бути однобічним і двостороннім, існує ще поняття спрямованого, або змушеного, антагонізму.
Антибіотики - органічні речовини, що синтезуються мікроорганізмами в природі для захисту від інтервенції інших видів мікроорганізмів, та володіють здатністю пригнічувати розвиток, або вбивати цих мікробів. Як правило, антибіотики виділяють з живих бактерій або грибів. Існує також велика кількість синтетичних антибіотиків, які відрізняються модифікаціями функціональних хімічних груп природніх антибіотиків. Такі модифіковані сполуки часто більш ефективні, або більш стійкі до нейтралізації, що виникає внаслідок набутої мікроорганізмами резистентності.
За хімічною структурою антибіотики об'єднують різноманітні групи сполук. Зокрема, сполуки, що блокують біосинтез білку на рибосомах; сполуки, що утворюють іоно-проникні канали у плазматичній мембрані, та ін.
Отже, сучасний арсенал антибіотиків постійно поповнюється новими, ефективними та відносно безпечними представниками та навіть класами препаратів. Найбільш відчутний прогрес у створенні нових антибіотиків спостерігався на початку 80-х років, коли у клініці з’явилися цефалоспорини ІІІ покоління, фторхінолони, інгібіторзахищені пеніциліни, трохи пізніше — напівсинтетичні макроліди.
Список використаних джерел
1. Атабеков И.Г. Практикум по общей вирусологии. — М.: Из-во Московского университета, 1981. — 191 с.
2. Батушкін В. В. Сучасні аспекти раціональної антибіотикотерапії// Клінічна фармакологія, фізіологія, біохімія. — 1999. — № 2 (Сучасна антимікробна терапія в клініці внутрішніх хвороб). — С. 187–204.
3. Белобородова Н. В., Богданов М. Б., Черненькая Т. В. Алгоритмы антибиотикотерапии (руководство для врачей). — М., 1999. — 143 с.
4. Березняков И. Г., Страшный В. В. Антибактериальные средства: стратегия клинического применения. — Харьков: Константа, 1997. — 199 с.
5. Бойко А Л. Экология вирусов растений. — К.: Вища шк., 1990. — 165 с.
6. Будзанівська І.Г., Поліщук В.П., Тивончук Т.П., Бойко А.Л. Зв'язок між наявністю антигенів фітовірусів в грунті, структурою грунтів та екологічним станом зовнішнього середовища // Вісник аграрної науки. — 1998. — №9. — С 61-63.
7. Вавилов Н.И. Иммунитет растений к инфекционным заболеваниям. - М: Наука, 1986. — 520 с.
8. Векірчик К.М. Практикум з мікробіології: Навч. посібник. – К.: Либідь, 2001. – 144 с.
9. Вершигора А.Ю., Бранцевич Л.Г., Василевская И.А. и др. Общая микробиология. — К.: Вища шк. Головное изд-во, 1988. — 342 с.
10. Вирощування екологічно чистої продукції рослинництва. /Под ред. Дегодюка Е.Г. — К.: Урожай, 1992. — 318 с.
11. Генкель Л. А. Микробиология с основами вирусологии. — М.: Просвещение, 1974. — 270 с.
12. Гиббс А., Харрисон Б. Основы вирусологии растений: Пер. с англ. — М.: Мир, 1978. — 430 с.
13. Гусев М. В., Минова Л. А. Микробиология. М.: Изд-во Моск. ун-та, 1992. - 448 с.
14. Егоров Н. С., Баранова И. П. Бактериоцины. Образование, свойства, применение// Антибиотики и химиотерапия. — 2000. — № 6. — С. 33–40.
15. Мишустин Е.Н., Емцев В.Т. Микробиология. – М.: Агропромиздат, 1987. – 368 с.
16. Мостовой Ю. М., Константинович Т. В., Демчук А. В. и др. Применение препарата амписульбин-КМП в лечении больных негоспитальными пневмониями// Клиническая антибиотикотерапия. — 2002. — № 4 (18). — С. 19–23.
17. Никитин А. В. Антибиотики и макроорганизм// Антибиотики и химиотерапия. — 2000. — № 12. — С. 31–36.
18. Покровский В. И. Инфекционная патология: вчера, сегодня, завтра// В сб.: Профилактика, диагностика и фармакотерапия некоторых инфекционных заболеваний (лекции для практикующих врачей). — М., 2002. — С. 7–17.
19. Сазыкин Ю. О. П. Эрлих и начало современной антимикробной химиотерапии// Антибиотики и химиотерапия. — 1999. — № 4. — С. 3–4.
20. Сазыкин Ю. О., Швец А. В., Иванов В. П. Антибиотикорезистентность и системы ативного выброса ксенобиотиков у бактерий// Антибиотики и химиотерапия. — 1999. — № 9. — С. 3–6.
21. Сидоренко С. В., Яковлев С. В. Бета-лактамные антибиотики/ В сб. науч. раб. "Атибиотики и атибиотикотерапия". — СПб: Бином, 2002. — 256 с.
22. Сучасні класифікації та стандарти лікування розповсюджених захворювань внутрішніх органів/ За ред. Ю. М. Мостового. — Вінниця, 2003. — 400 с.